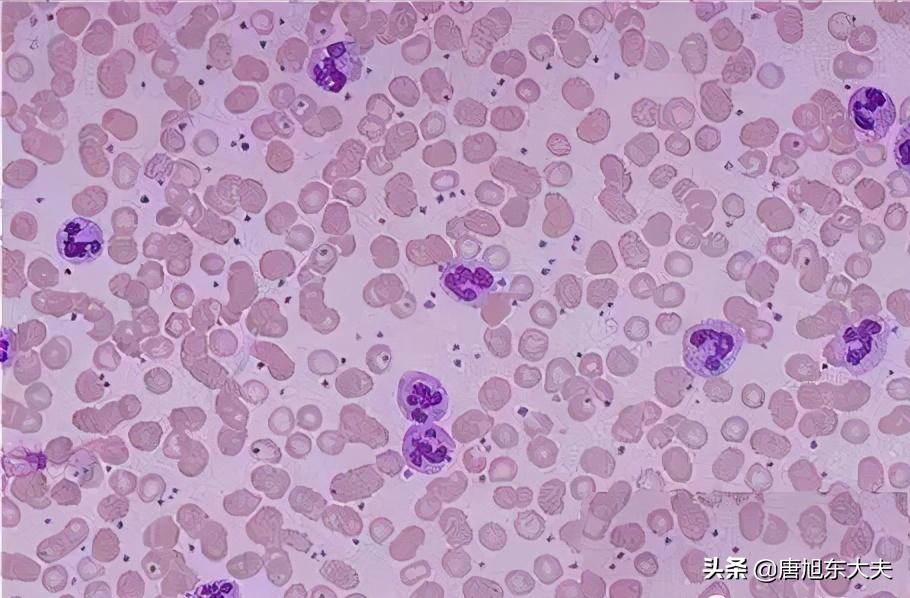
Image

五种容易与血小板减少性紫癜混淆的疾病
发布时间:2024-09-16
血小板减少性紫癜(ITP)是一种常见的出血性疾病,其特点是外周血中血小板减少。然而,ITP的诊断并非易事,因为它的临床表现与其他几种疾病极为相似,容易造成误诊。以下是5种最易与ITP混淆的疾病,以及它们之间的区别。
首先,溶血尿毒综合征(HUS)是ITP的一个重要鉴别诊断。HUS主要表现为微血管病性溶血性贫血、血小板减少和急性肾功能衰竭。与ITP不同的是,HUS患者通常有明显的肾功能损害,血尿素氮和肌酐水平显著升高。此外,HUS多见于儿童,常与腹泻有关,而ITP则更多见于成人。
其次,弥散性血管内凝血(DIC)也是需要与ITP鉴别的疾病。DIC是一种严重的凝血功能障碍,可导致全身多器官出血。与ITP相比,DIC患者除了血小板减少外,还会有凝血因子消耗的表现,如凝血酶原时间(PT)和活化部分凝血活酶时间(APTT)延长,纤维蛋白原水平降低。此外,DIC常继发于严重感染、创伤或恶性肿瘤等疾病,而ITP则多为原发性疾病。
第三,系统性红斑狼疮(SLE)是一种自身免疫性疾病,其血小板减少的表现可能与ITP相似。然而,SLE患者通常还有其他系统受累的表现,如面部蝶形红斑、关节炎、肾炎等。实验室检查可发现抗核抗体、抗双链DNA抗体等自身抗体阳性,而ITP患者则通常没有这些抗体。
第四,Evans综合征是一种罕见的自身免疫性疾病,其特点是同时存在自身免疫性溶血性贫血和ITP。与单纯ITP相比,Evans综合征患者除了血小板减少外,还会有贫血的表现,网织红细胞计数升高,血清乳酸脱氢酶水平升高。此外,Evans综合征患者可能有更严重的免疫系统异常,需要更积极的免疫抑制治疗。
最后,妊娠高血压综合征(子痫前期)在孕妇中可能与ITP混淆。子痫前期患者可能会出现血小板减少,但通常还伴有高血压、蛋白尿等症状。此外,子痫前期患者的血小板减少程度通常较轻,很少低于50×10^9/L,而ITP患者的血小板计数常低于30×10^9/L。
对于ITP的诊断,关键在于排除上述疾病。根据2022年中国指南,ITP的诊断标准包括:血小板计数低于100×10^9/L,骨髓检查显示巨核细胞数量正常或增加,排除其他可能导致血小板减少的原因。此外,血小板相关抗体(PAIg)和血小板相关补体(PAC3)检测阳性可支持ITP的诊断。
ITP的治疗原则是提高血小板计数到安全水平,而不是使其恢复正常。一线治疗包括糖皮质激素和静脉输注丙种球蛋白(IVIg)。对于难治性ITP,二线治疗包括脾切除术和免疫抑制剂。近年来,新型药物如促血小板生成素受体激动剂也显示出良好的疗效。
总之,ITP的诊断需要仔细鉴别与其他可能导致血小板减少的疾病。只有通过全面的临床评估和实验室检查,才能做出准确的诊断,从而为患者提供最佳的治疗方案。